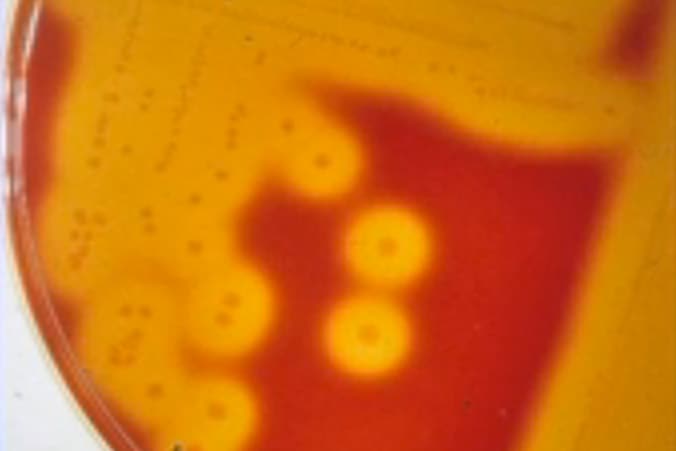

Equine Abortion Diagnosis and Beyond
Learn about the latest microbiological methods for detecting the cause of a mare’s abortion with Dr. Erdal Erol of the University of Kentucky’s Veterinary Diagnostic Laboratory.
Learn about the latest microbiological methods for detecting the cause of a mare’s abortion with Dr. Erdal Erol of the University of Kentucky’s Veterinary Diagnostic Laboratory.
Flu, equine herpesviruses 1 and 4, and strangles commonly cause upper respiratory tract problems in horses with coughing, runny nose, and fever. How can you tell which one your horse has, and what can you do to prevent these diseases?
A Thoroughbred filly undergoes arthroscopic surgery to remove a bone chip from her left hind fetlock, increasing her chances of staying sound for horse racing. Dr. Chris Johnson of Woodford Equine Hospital in Versailles, Ky, explains the procedure.
Discussion of equine herpesvirus-1 neurologic disease and abortion, prevention, treatment and the latest research on preventing this disease in horses by Dr. Paul Lunn of Colorado State University.
Compounded or customized medications fulfill a critically important role in horse health care; however, these tailored medications aren’t always what compounders claim them to be, and some are illegal.
Learn how weather, horse age, stocking density, and practices such as dragging and rotating pastures can affect your horse’s worm burden. Dr. Lori Bidwell also gives management tips for minimizing worm populations in your horses.
Learn about the May 2011 outbreak of equine herpesvirus-1 (EHV-1) neurologic disease, along with background information on EHV-1 and recommendations for veterinarians to help diagnose, treat, and educate owners about this disease.
The May 2011 outbreak of the sometimes fatal neurologic disease caused by equine herpesvirus-1 (EHV-1) has generated widespread concern throughout the horse industry. Learn about recognizing, treating, and preventing this disease in this free webinar
Learn how your horse’s back works and causes of and treatments for equine back pain, with biomechanics researcher Dr. Hilary Clayton of Michigan State University.
What internal parasites can affect horses, and how much damage can they cause? How do we fight them? Dr. Lori Bidwell explains in this video.
Learn about equine metabolic syndrome and its relationship to laminitis, recognizing and managing at-risk horses to prevent laminitis, and more with Dr. Raymond Geor of Michigan State University.
Why and when should you geld or castrate a stallion, and what’s involved in the procedure? How should you care for the new gelding afterward? Dr. Christy Corp-Minamiji of Davis, California, explains.
Dr. Stephen White of the University of California, Davis, discusses common skin problems in horses resulting from bacterial/fungal infections, such as pyoderma, vasculitis, and Staphylococcus infections. Treatments are also covered.
Learn what first-aid supplies you should have on hand for the humans working in and visiting your barn with Dr. Roberta Dwyer of the University of Kentucky’s Gluck Equine Research Center.
Learn how vaccines work, which ones your horse should have, and reactions to watch out for with Dr. Dale Brown of Rood & Riddle Equine Hospital in Lexington, Ky.
What you should have in a first-aid kit for your horses, with Dr. Roberta Dwyer of the University of Kentucky’s Gluck Equine Research Center.
Stay on top of the most recent Horse Health news with
"*" indicates required fields